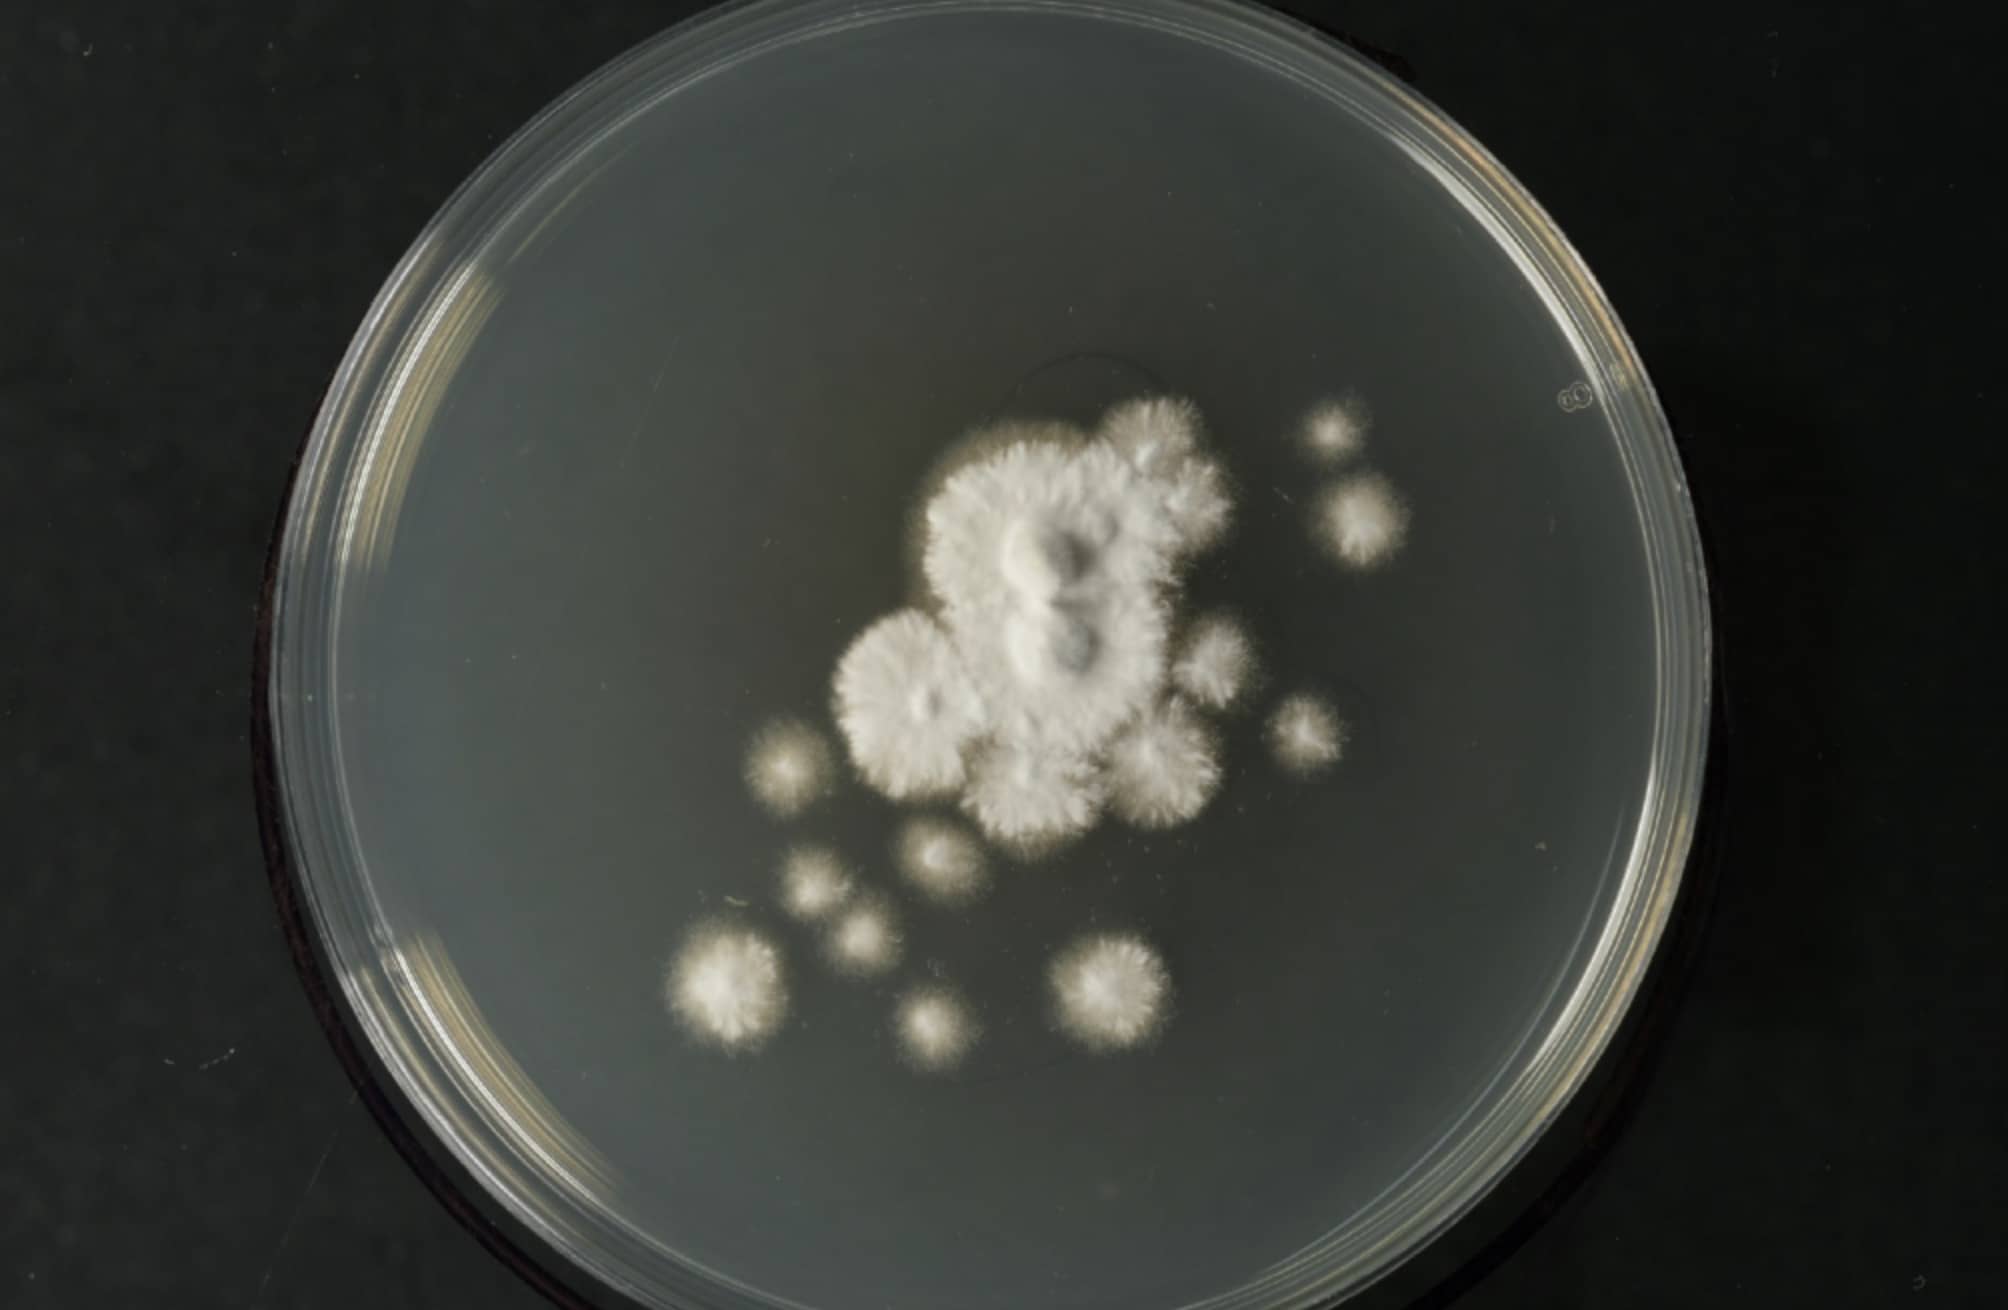

Tū Wairua
Traditional Māori healing practices
Integration of rongoā Māori with psychedelic assisted therapy
About
This project is led by the Rangiwaho Marae community with support from an inter-disciplinary team of researchers and practitioners. Based at Rangiwaho Marae in Te Tairāwhiti, a community with a high Māori population and a significant burden of PMU, the project aims to develop a decolonised, culturally-appropriate approach to PAT to explore the efficacy of psilocybin in treating PMU.
Mission
This Māori-led project is led by the Rangiwaho Marae community with support from an inter-disciplinary team of researchers and practitioners. Based at Rangiwaho Marae in Te Tairāwhiti, a community with a high Māori population and a significant burden of PMU, the project aims to develop a decolonised, culturally-appropriate approach to PAT to explore the efficacy of psilocybin in treating PMU.